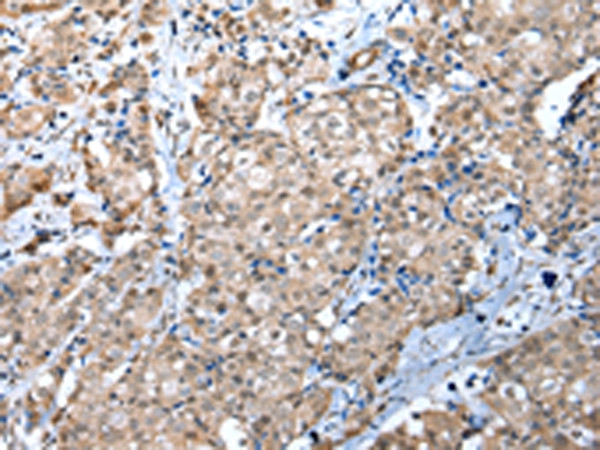
WDR4 Antibody in Immunohistochemistry (Paraffin) (IHC (P))

Search
Invitrogen
WDR4 Polyclonal Antibody
{{$productOrderCtrl.translations['antibody.pdp.commerceCard.promotion.promotions']}}
{{$productOrderCtrl.translations['antibody.pdp.commerceCard.promotion.viewpromo']}}
{{$productOrderCtrl.translations['antibody.pdp.commerceCard.promotion.promocode']}}: {{promo.promoCode}} {{promo.promoTitle}} {{promo.promoDescription}}. {{$productOrderCtrl.translations['antibody.pdp.commerceCard.promotion.learnmore']}}
产品信息
PA5-51163
种属反应
宿主/亚型
分类
类型
抗原
偶联物
形式
浓度
规格
纯化类型
保存液
内含物
保存条件
运输条件
RRID
产品详细信息
The antibody detects endogenous levels of total WDR4 protein.
靶标信息
Required for 7-methylguanosine modification of tRNA. This protein is a member of the WD repeat protein family. WD repeats are minimally conserved regions of approximately 40 amino acids typically bracketed by gly-his and trp-asp (GH-WD). which may facilitate formation of heterotrimeric or multiprotein complexes. Members of this family are involved in a variety of cellular processes. including cell cycle progression. signal transduction. apoptosis. and gene regulation. This protein is excluded as a candidate for a form of nonsyndromic deafness (DFNB10). but is still a candidate for other disorders mapped to 21q22.3 as well as for the development of Down syndrome phenotypes. Alternative splicing of this gene generates at least 3 transcript variants. two of which diverge at the 3' UTR and thus encode the same protein products.
仅用于科研。不用于诊断过程。未经明确授权不得转售。
篇参考文献 (0)
生物信息学
蛋白别名: hWH; mWH; Protein Wuho homolog; TRM82 tRNA methyltransferase 82 homolog; tRNA (guanine-N(7)-)-methyltransferase non-catalytic subunit WDR4; tRNA (guanine-N(7)-)-methyltransferase subunit WDR4; unnamed protein product; WD repeat domain 4; WD repeat domain 4 METTL1 scaffold protein; WD repeat-containing protein 4; WD40 repeat protein 4
基因别名: AI415180; AI448349; D530049K22Rik; GAMOS6; hWH; MIGSB; TRM82; TRMT82; WDR4; Wuho
UniProt ID: (Human) P57081, (Mouse) Q9EP82
Entrez Gene ID: (Human) 10785, (Mouse) 57773